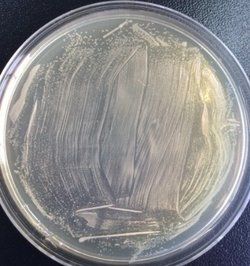

基本介紹
藍白斑篩選是一種基因工程常用的重組菌篩選方法。
野生型大腸桿菌產生的β-半乳糖苷酶可以將無色化合物X-gal(5-溴-4-氯-3-吲哚-β-D-半乳糖苷)切割成半乳糖和深藍色的物質5-溴-4-靛藍。有色物質可以使整個培養菌落產生顏色變化,而顏色變化是鑑定和篩選的最直觀有效的方法。
白斑篩選
大腸桿菌β-半乳糖苷酶可分成2部分即α肽段(N-端的146個aa)和C-段。α肽段的基因位於載體上並含有不影響其ORF(open reading )的多克隆位點(MCS),而C-段的基因位於工程菌E. coli DH5α上。二者在同一菌株中表達時,菌株中的C-段與載體上的α肽段互補而具有酶活性,能將無色化合物X-gal(5-溴-4-氯-3-吲哚-β-D-半乳糖苷)切割成半乳糖和深藍色的物質5-溴-4-靛藍。在MCS上插入新基因將會改變其ORF而使得載體上的α肽段不能與菌株中的C-段互補而不能無色化合物X-gal(5-溴-4-氯-3-吲哚-β-D-半乳糖苷)切割成半乳糖和深藍色的物質5-溴-4-靛藍產生白斑。選擇轉入的陽性克隆即選擇白斑。
白斑篩選
設計適用於藍白斑篩選的基因工程菌為β-半乳糖苷酶缺陷型菌株。這種宿主菌的
染色體基因組中編碼β-半乳糖苷酶的基因突變,造成其編碼的β-半乳糖苷酶失去正常N段一個146個胺基酸的短肽(即α肽鏈),從而不具有生物活性,即無法作用於X-gal產生藍色物質。用於藍白斑篩選的載體具有一段稱為lacz'的基因,lacz'中包括:一段β-半乳糖苷酶的啟動子;編碼α肽鏈的區段;一個多克隆位點(MCS)。MCS位於編碼α肽鏈的區段中,是外源DNA的選擇性插入位點,但其本身不影響載體編碼α肽鏈的功能活性。雖然上述缺陷株基因組無法單獨編碼有活性的β-半乳糖苷酶,但當菌體中含有帶lacz'的質粒後,質粒lacz'基因編碼的α肽鏈和菌株基因組表達的N端缺陷的β-半乳糖苷酶突變體互補,具有與完整β-半乳糖苷酶相同的作用X-gal生成藍色物質的能力,這種現象即α-互補。
操作中,添加IPTG(異丙基硫代-β-D-半乳糖苷)以激活lacz'中的β-半乳糖苷酶的啟動子,在含有X-gal的固體平板培養基中菌落呈現藍色。以上是攜帶空載體的菌株產生的表型。當外源DNA(即目的片段)與含lacz'的載體連線時,會插入進MCS,使α肽鏈讀碼框破壞,這種重組質粒不再表達α肽鏈,將它導入宿主缺陷菌株則無α互補作用,不產生活性β-半乳糖苷酶,即不可分解培養基中的X-gal產生藍色,培養表型即呈現白色菌落。
實驗中,通常藍白篩選是與抗性篩選一同使用的。含X-gal的平板培養基中同時含有一種或多種載體所攜帶抗性相對應的抗生素,這樣,一次篩選可以判斷出:未轉化的菌不具有抗性,不生長;轉化了空載體,即未重組質粒的菌,長成藍色菌落;轉化了重組
質粒的菌,即目的重組菌,長成白色菌落。
白斑篩選
⑴、受體細胞
轉化的受體細胞一般是限制-修飾系統缺陷的突變株,即不含限制性內切酶和甲基化酶的突變株,它可容忍外源DNA分子進入體內並穩定地遺傳給後代。
另外還應根據載體的性質及實驗的目的選擇合適的宿主。
此外,受體細胞生長狀態和密度也很重要。不要使用經過多次轉接或儲存於4℃的培養菌。細胞生長密度以剛進入對數生長期時為好,密度過高或不足均會影響轉化率。
⑵、載體DNA和重組DNA方面
載體本身性質決定了轉化的高低,不同的載體DNA轉化同一受體細胞,其轉化效率不同。載體的空間構象也有明顯影響,超螺鏇結構的載體質粒往往有較高的轉化率,經體外酶切連線操作後的載體DNA或重組DNA由於空間上難以恢復,其轉化率常比cccDNA低兩個數量級。對以質粒為載體的重組分子而言,分子量大的轉化效率低。
⑶、操作方面
感受態細胞的製備對轉化率影響較大。一般未經特殊處理的培養細胞對重組DNA分子不敏感,難以轉化成功。為防止雜菌和雜DNA的污染,整個操作均應在無菌條件下進行,所有器皿最好是新的,並經高壓滅菌處理,所有試劑也都要滅菌處理。
⑷、轉化體系中重組DNA的濃度與純度
轉化體系中重組DNA的濃度與純度對轉化率也有一定影響。在一定濃度範圍內,濃度越高,轉化率越高,重組DNA純度越高,轉化率越高。
⑸、外源基因與宿主染色體的同源性
外源基因來源與宿主親緣關係越近,越易整合到宿主染色體中,轉化率越高,否則易被宿主核酸酶降解而降低轉化率。
白斑篩選
實驗試劑
X-gal:2%母液(用二甲基甲醯胺配製,包以鋁箔或黑紙以防止受光照被破壞,-20℃保存備用),工作濃度20ul/20ml平板;
氨苄青黴素(Amp):用無菌水配製成100mg/ml母液,置-20℃冰櫃保存。工作濃度100ug/ml;
IPTG:母液100mmol/L,-20℃冰櫃保存。工作濃度40ul/20ml平板;
LB液體培養基:1%蛋白腖,0.5%酵母提取物,1%NaCl,用NaOH調pH到7.2,121℃滅菌20min備用。固體LB培養基則在LB液體培養基中添加1.5%~2%瓊脂,滅菌後備用;
含Amp的LB固體培養基:將配好的LB固體培養基高壓滅菌後冷卻至60℃左右,加入Amp儲存液,使終濃度為100ug/ml,搖勻後鋪板;
大腸桿菌DH5a。
試劑的作用
X-gal(5-溴-4-錄-3-吲哚-β-半乳糖苷):一種人工化學合成的半乳糖苷,可被β-半乳糖苷酶水解產生蘭色化合物。
IPTG:異丙基硫代半乳糖苷,很強的誘導劑,不被細菌代謝而十分穩定,它可誘導LacZ的表達。
實驗器具
超淨工作檯;恆溫水浴鍋;製冰機;微量移液器;恆溫搖床;常溫離心機;恆溫生化培養箱;冰櫃;培養皿;玻璃刮鏟。
實驗步驟
⑴、取4ul連線產物加入50ul感受態細胞中,用槍輕輕吹打均勻,冰浴30min。
⑵、將管置於水浴鍋中42℃水浴熱激90sec,立刻放置冰上2min。
⑶、加入1ml 37℃預熱的不含任何抗生素的LB培養基,混勻。
⑷、將管置於恆溫搖床上37℃振盪培養1h。
⑸、將管置於離心機中3000rpm離心5min。
⑹、棄900ul上清,餘下約100ul上清,用槍輕輕吹勻,用於塗板。
⑺、在一含氨苄青黴素的LB平板上,加入20μl 20mg/ml X-gal和40μl100mmol/L IPTG。
⑻、將玻璃刮鏟過火滅菌後伸入培養平板中,待其冷卻後均勻塗布平板,玻璃刮鏟過火滅菌後置於酒精中備用,平板於室溫放置30min備用。
⑼、將前述所得含重組子的菌液吸至製備好的含X-gal的平板上,用玻璃刮鏟均勻塗布。將平板置於生化培養箱中正面放置30min後,再倒置,於37℃培養過夜。
注意事項
1、質粒的質量和濃度
用於轉化的質粒DNA應主要是超螺鏇態DNA(cccDNA)。轉化效率與外源DNA的濃度在一定範圍內成正比,但當加入的外源DNA的量過多或體積過大時,轉化效率就會降低。一般情況下,DNA溶液的體積不應超過感受態細胞體積的10%。
2、防止雜菌和雜DNA的污染
整個操作過程均應在無菌條件下進行, 所用器皿, 如離心管, tip頭等最好是新的,並經高壓滅菌處理,所有的試劑都要滅菌,且注意防止被其它試劑、DNA酶或雜DNA所污染,否則均會影響轉化效率或雜DNA的轉入,為以後的篩選、鑑定帶來不必要的麻煩。
3、顯色反應的時間
需要將平板放入4℃冰櫃中3-4h,使得顯色反應充分。
4、平板的塗布
菌液塗平板的時候要避免來回塗布,否則過多的機械擠壓塗布會導致細胞破裂,影響轉化效率。